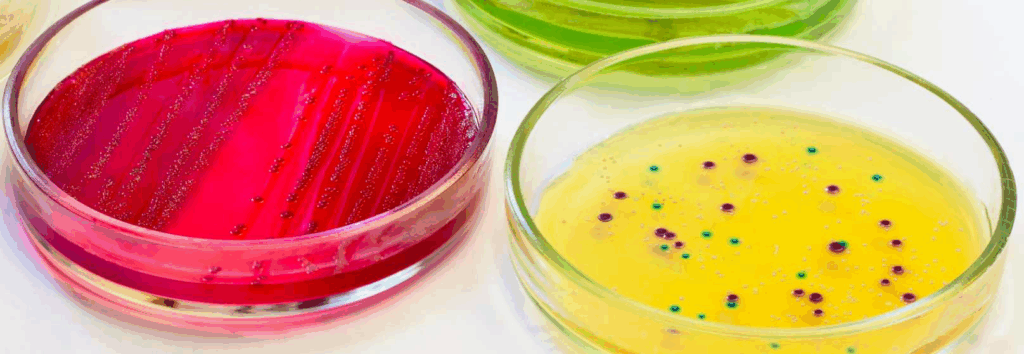

A chi è consigliato questo screening microbiologico?
Il microbiota intestinale è coinvolto nella salute della pelle e nella salute in generale.
Tutte le patologie cutanee (psoriasi, acne, dermatite, orticaria, eczema), condizioni di malassorbimento, calo di peso, difficoltà nello scendere di peso, diradamento, caduta dei capelli e tutte le malattie infiammatorie croniche e autoimmuni (fibromialgia, sindrome dell’intestino irritabile – SII, morbo di Crohn, rettocolite ulcerosa, Hashimoto, artrite reumatoide, artrite psoriasica, spondiloartrite, sclerodermia, diabete di tipo 1, lupus eritematoso sistemico (LES), sclerosi multipla, celiachia, sindrome di Sjögren, vasculiti, epatite autoimmune, alopecia areata, miastenia Gravis, miopatia necrotizzante autoimmune, neuropatia delle piccole fibre (NPF), morbo di Graves) – che contano oltre 100 diverse manifestazioni – vanno affrontate a partire dall’intestino.
L’infiammazione nasce spesso da una contaminazione batterica specifica su cui bisogna intervenire con approcci nutrizionali e nutraceutici.
È stata sviluppata un’indagine sul microbiota, creata appositamente, per fornire informazioni veritiere e utili, supportata anche da aromatogramma e antimicogramma per un trattamento personalizzato ed efficace.
Da un semplice campione fecale, viene ricercata tutta la flora patogena, e ad ogni patogeno viene affiancato l’aromatogramma, un’indagine alternativa all’uso degli antibiotici.
Tra i patogeni ricercati: Candida ALBICANS, Candida KRUSEI, Candida LUSITANIAE, Candida AURIS, Candida DUBLINIENSI, Candida FAMATA, Candida GLABRATA, Candida GUILLERMONDII, Candida PARAPSILOSIS, Candida TROPICALIS, CAMPILOBACTER (C. jejuni, C. coli e C. lari), ESCHERICHIA COLI O157 (EHEC) ed ENTEROTOXIGENIC (ETEC), SALMONELLA, SHIGELLA, HELICOBACTER PYLORI (ricerca antigene fecale), ACINETOBACTER, AEROMONAS, BURKHOLDERIA, CITROBACTER, ENTEROBACTER, KLEBSIELLA, MORGANELLA, PROTEUS, PROVIDENCIA, PSEUDOMONAS, SERRATIA, STAPHYLOCOCCUS, ENTEROCOCCUS, STREPTOCOCCUS, LACTOBACILLUS, STREPTOCOCCUS AGALACTIAE e EUBACTERIUM RECTALE, STREPTOCOCCUS SALIVARIUS, STREPTOCOCCUS TERMOPHILUS e S. SANGUINIS, ASPERGILLUS, ASPERGILLUS NIGER, ASPERGILLUS fumigatus, PENICILLUM, SACCAROMICES, GEOTRICHUM.
Aromatogramma effettuato su: berberina, basilico, rosmarino, cajeput, geranio, menta piperita, timo, origano, tea tree, garofano, cannella.
Antimicogramma effettuato con: Nistatina, Amfotericina, Flucitosina, Econazolo, Ketoconazolo, Clotrimazolo, Miconazolo, Itraconazolo, Voriconazolo, Fluconazolo.
All’interno del kit spedito, sono inserite tutte le informazioni per lo svolgimento del test e le istruzioni per la rispedizione del kit.